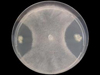

|
미국 연구진, DHA가 염증성 질환을 치료하는 기작 밝혀...
|
2012/05/02 |
|
미국 연구진, DHA가 염증성 질환을 치료하는 기작 밝혀 || DNA 감지 등 초고감도 바이오칩 양산기술 개발 - 반도체 양산 공정 활용해 || 심방세동 관련 새 유전자 6개 발견 - PRRX1, CAV1 등 총 9개 규명돼 || 생물학적 이미지를 향상시키기 위한...
|
|

|
알코올 중독 치료, 약물없이 쌀로 치료한다 - '밀양263' ...
|
2012/04/30 |
|
알코올 중독 치료, 약물없이 쌀로 치료한다 - '밀양263' || 신경줄기세포로 분화를 도와주는 작은 분자들의 발견 || KIST, 인니에 바이오에탄올 시험공장 세웠다. || DNA 한가닥만 자르는 `유전자 가위` - 줄기세포 치료 정확성 기대 || 지방간 질...
|
|

|
식물 관련 질환을 억제하는 리소박터(Lysobacter) ...
|
2012/04/28 |
|
식물 관련 질환을 억제하는 리소박터(Lysobacter) || 아주 위험한 살모넬라 발견 || 향신료 오레가노, 전립선암세포 파괴 || 비타민D는 혈압강하제 || 항우울제, 得보다 失 클수도 || 뜨거운 간헐천에서 생성된 잡종 유전체 || 고체상 나노포어 센서의 ...
|
|

|
ISS발 괴 미생물체 사건-골칫거리로 떠오른 우주 미생물 ...
|
2012/04/26 |
|
ISS발 괴 미생물체 사건-골칫거리로 떠오른 우주 미생물 || 바이러스가 세포 안으로 들어가는 것을 모방하는 나노결정 프로브 || 아미노산 강유전체 성질 밝혀지다 || 항암 光치료, 효율은 쑥 가격은 뚝최희철 교수팀, 광민감제 새 기술 개발 || 혈관내피세포 치료...
|
|
|
피 한 방울로 '암 진단' - 나노바이오 센서 개발...
|
2012/04/26 |
|
피 한 방울로 '암 진단' - 나노바이오 센서 개발 || BRCA1 변이유전자 남성 전립선암 위험 4배 || 美광우병 발견…닭고기ㆍ쇠고기株 급등락 '명암' || 임신촉진제, 백혈병 아이 출산 위험 || 홍합 접착력 이용, 뼈 재생효과 4배 높여 - 기능...
|
|
|
